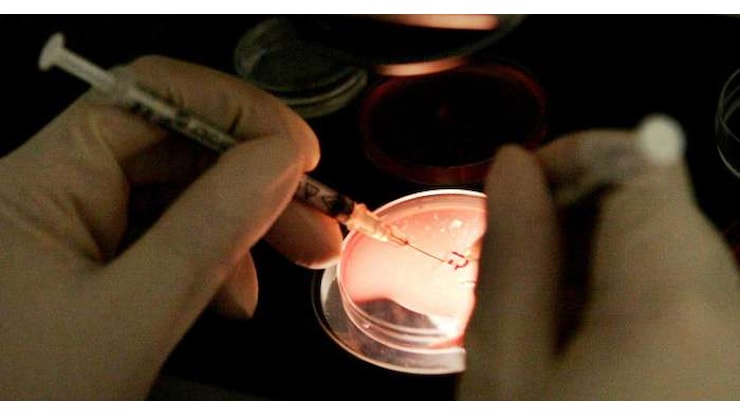
Media, 200 bebè nati in Europa da un donatore di sperma a rischio cancro - www.altoadige.it

Danimarca, una mutazione genetica ereditaria da un donatore mette a rischio quasi 200 bambini concepiti con fecondazione assistita

Articolo Precedente

Articolo Successivo

 Redazione Salute
-
Un'inchiesta giornalistica condotta da un consorzio di quattordici emittenti pubbliche europee, tra cui la Bbc, ha portato alla luce un caso che solleva profonde questioni etiche e sanitarie nel settore delle procreazioni medicalmente assistite.
Redazione Salute
-
Un'inchiesta giornalistica condotta da un consorzio di quattordici emittenti pubbliche europee, tra cui la Bbc, ha portato alla luce un caso che solleva profonde questioni etiche e sanitarie nel settore delle procreazioni medicalmente assistite.
Secondo quanto accertato, lo sperma di un unico donatore danese, portatore di una specifica mutazione del gene TP53, è stato utilizzato per concepire quasi duecento bambini in diversi paesi del continente.
La mutazione in questione, che il donatore inconsapevolmente veicolava, è associata alla sindrome di Li-Fraumeni, una condizione ereditaria che incrementa in modo drammatico, fino a toccare una probabilità del novanta per cento, il rischio di sviluppare tumori nel corso dell'esistenza.
La banca del seme danese che ha commercializzato il materiale biologico, la cui identità non è stata resa pubblica, ha proceduto alla distribuzione prima di identificare l'anomalia genetica. repubblica +3
La gravità della mutazione e la diffusione del materiale biologico
La sindrome di Li-Fraumeni, provocata appunto da alterazioni nel gene oncosoppressore TP53, è riconosciuta dalla comunità scientifica internazionale come una delle patologie oncogenetiche più severe, poiché predispone a un ampio spettro di neoplasie, che possono manifestarsi anche in età giovanile.
La rivelazione dell'inchiesta, la quale ha evitato di fornire dettagli espliciti su singoli casi di cronaca nera pur confermando che alcuni dei nati sarebbero già deceduti per tumore, getta una luce inquietante sui meccanismi di controllo sanitario applicati alle donazioni di gameti.
Il materiale, diffuso sotto lo pseudonimo di "Kjeld", ha infatti varcato i confini nazionali, complicando ulteriormente la ricostruzione dei casi e la possibilità di un intervento sanitario coordinato e tempestivo a tutela della salute dei minori coinvolti. repubblica +3
Le implicazioni per i nati e il quadro normativo frammentato
Il fatto che circa duecento individui, sparsi per l'Europa, condividano ora lo stesso elevatissimo rischio oncologico eredito da un'unica fonte biologica pone interrogativi senza precedenti sulle responsabilità delle banche del seme e sull'efficacia delle normative transfrontaliere.
In Danimarca, paese noto per una legislazione relativamente permissiva in materia e meta per ciò definita "fertility travel", i donatori sono sottoposti a screening genetici, ma l'estensione e la profondità di questi test possono variare, lasciando potenziali margini per situazioni come quella emersa.
L'identificazione della mutazione è avvenuta, stando ai fatti, solo in un secondo momento, quando ormai le provette avevano già dato origine a nuove vite, evidenziando un ritardo diagnostico dalle conseguenze potenzialmente gravissime per coloro che ne sono stati coinvolti. altoadige +3
La necessità di trasparenza e di rigorosi protocolli di controllo
L'episodio, al di là delle specifiche vicende giudiziarie che potrebbero scaturirne, impone una riflessione stringente sulla trasparenza nei processi di donazione e sulla necessità di armonizzare, a livello europeo, protocolli di screening genetico obbligatori e aggiornati.
Le famiglie coinvolte, molte delle quali probabilmente all'oscuro del pericolo fino alle rivelazioni investigative, si trovano ad affrontare non solo l'angoscia per la salute dei propri figli, ma anche la complessità di ottenere una piena informazione medica e un adeguato supporto.
La vicenda dimostra come, in assenza di una regolamentazione rigorosa e uniforme, il desiderio legittimo di genitorialità possa scontrarsi con rischi sanitari imprevisti e di vasta portata, rendendo indispensabile un riesame complessivo delle garanzie offerte ai fruitori di queste tecniche di procreazione. dire +3




